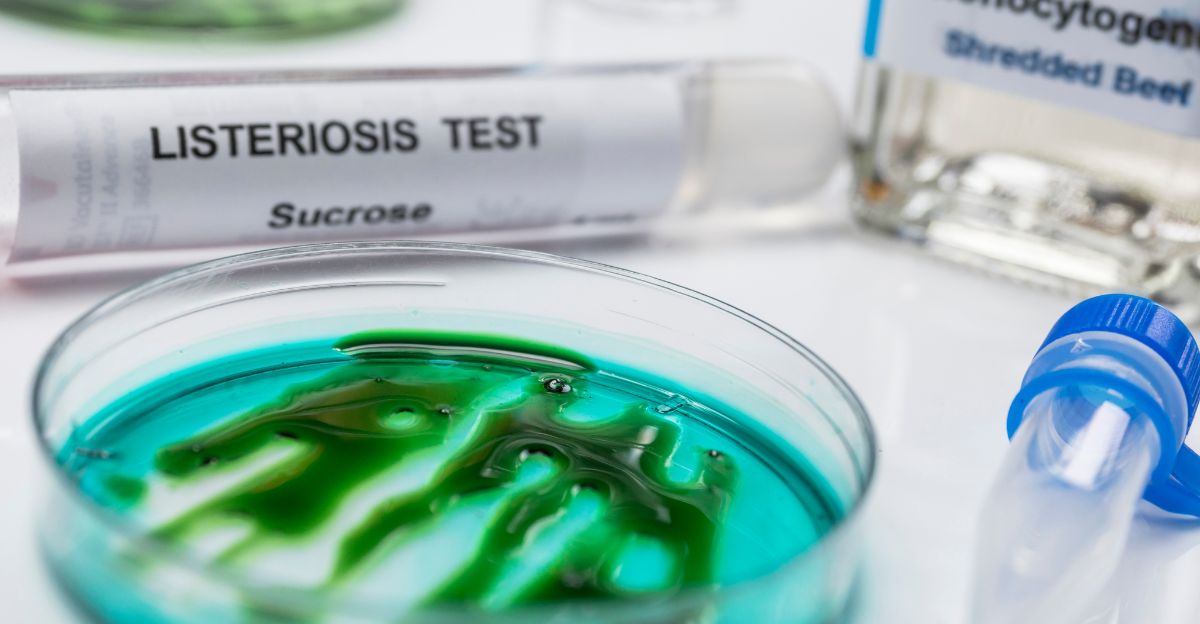

Un devastador brote de listeria afectó a 15 estados de EE. UU. en septiembre y octubre de 2025, impactando a grandes minoristas como Walmart, Trader Joe’s y Kroger.
Las autoridades sanitarias reportan cuatro muertes y al menos veinte hospitalizaciones, la mayoría entre adultos mayores y personas con sistemas inmunológicos debilitados.
Según el CDC y la FDA, Walmart inició uno de los retiros de alimentos más grandes en los últimos años, con el objetivo de prevenir más casos a medida que se multiplicaban los focos de infección. Este evento sacudió a las industrias alimentaria y minorista en todo el país.
La Fuente De La Contaminación
Las investigaciones rápidamente rastrearon el brote hasta comidas de pasta precocida producidas por FreshRealm, suministradas a nivel nacional a Walmart, Kroger y Trader Joe’s.
Los inspectores de la FDA encontraron fallas en la higiene y un control insuficiente de patógenos en las instalaciones del proveedor; se detectó el patógeno Listeria monocytogenes en las marcas Marketside y Home Chef.
Múltiples fallas de los proveedores permitieron una rápida propagación en varios estados, revelando vulnerabilidades críticas en las cadenas modernas de suministro de alimentos.
Efectos Inmediatos en Los Consumidores

Se instó a los consumidores de todo el país a retirar de sus hogares las comidas de pasta retiradas del mercado—como la linguini con albóndigas de carne Marketside y el pollo Alfredo Home Chef—ante las advertencias sobre las graves consecuencias para la salud de la bacteria.
Las solicitudes de reembolso aumentaron, especialmente entre las poblaciones vulnerables, mientras que las autoridades sanitarias emitieron orientaciones sobre el monitoreo de síntomas y la búsqueda de asistencia médica. Muchas familias expresaron preocupación por problemas más amplios de seguridad alimentaria.
Reacción De Los Grandes Minoristas

Walmart lideró un retiro coordinado en más de 3,000 ubicaciones, eliminando todas las comidas potencialmente contaminadas y publicando alertas en línea y en las tiendas.
Kroger, Albertsons y Trader Joe’s siguieron su ejemplo, utilizando redes sociales, comunicados de prensa y líneas de atención al cliente para abordar las preocupaciones de los clientes.
Los minoristas también lanzaron portales detallados de preguntas frecuentes e información de seguridad, destacando la magnitud de la crisis a medida que aparecían nuevos casos.
Los Estados Afectados

Las muertes asociadas al brote de listeria ocurrieron en Utah, Illinois, Michigan y Texas. Se reportaron infecciones confirmadas en los siguientes 15 estados: California (2 casos), Florida (1), Illinois (1), Indiana (1), Luisiana (2), Michigan (2), Minnesota (1), Misuri (1), Nevada (1), Carolina del Norte (1), Ohio (1), Carolina del Sur (1), Texas (3), Utah (1) y Virginia (1). El CDC señala que estas cifras solo reflejan los casos conocidos y que el alcance real del brote podría ser mayor.
Conmoción en El Comercio Internacional De Alimentos

Surgieron implicaciones globales cuando las autoridades estadounidenses aumentaron las inspecciones de ingredientes importados asociados con comidas listas para consumir.
Los exportadores europeos y asiáticos se preocuparon por retrasos adicionales y requisitos de pruebas más estrictos para los envíos de alimentos.
Los mercados respondieron endureciendo la selección de proveedores e innovando con registros para estándares de trazabilidad global.
La Limpieza Se Expande en Las Instalaciones De Freshrealm

Tras el retiro nacional, las instalaciones vinculadas a FreshRealm—el proveedor de numerosas comidas de pasta retiradas—fueron sometidas a procedimientos integrales de limpieza y saneamiento.
La cobertura noticiosa confirmó que se implementaron protocolos de higiene mejorados y pruebas ambientales mientras los reguladores federales investigaban el origen del brote de listeria.
Estas medidas son estándar en la respuesta a brotes para garantizar que los entornos de producción de alimentos cumplan con los requisitos de seguridad antes de reanudar las operaciones completas.
Mejoras en La Seguridad Alimentaria

Tras este y otros grandes retiros, el Congreso celebra frecuentemente audiencias públicas y examina la supervisión de la FDA en la prevención de enfermedades transmitidas por alimentos.
Legisladores de ambos partidos han debatido medidas para fortalecer el cumplimiento de la seguridad alimentaria, mejorar los procedimientos de retiro y aumentar los recursos de la FDA.
Los llamados a regulaciones más estrictas y los debates bipartidistas suelen seguir a cualquier brote nacional importante, ya que los responsables de políticas equilibran las necesidades de salud pública con las realidades de la industria.
Inflación en Alimentos Listos Para Consumir

La inflación de los alimentos aumentó ligeramente debido a las interrupciones en la cadena de suministro y la repentina escasez de productos retirados. Los minoristas compensaron con descuentos en alternativas frescas y congeladas, pero los aumentos de precios en alimentos de conveniencia persistieron a medida que la demanda cambiaba. Los expertos dicen que los picos podrían durar meses mientras las redes de distribución se adaptan y los costos se recalculan.
Las Estrategias Minoristas Se Orientan Hacia La Garantía

Durante el brote de listeria, Walmart respondió retirando todas las comidas de pasta listas para consumir potencialmente contaminadas de sus tiendas en todo el país.
Los productos afectados incluyeron la linguini Marketside con albóndigas de carne y salsa marinara, que dio positivo por Listeria.
En coordinación con las autoridades sanitarias, Walmart publicó alertas públicas, instó a los clientes a revisar y desechar artículos específicos y trabajó con los proveedores para investigar la contaminación.
Estas acciones son consistentes con los procedimientos estándar de la industria para proteger a los consumidores durante incidentes de seguridad alimentaria.
Revisión De Menús Y Abastecimiento en Restaurantes

En respuesta al brote y al retiro resultante de comidas de pasta precocida, muchos restaurantes retiraron rápidamente los productos identificados de sus menús.
Los avisos de salud llevaron a los operadores de servicios de alimentos a revisar y fortalecer los procedimientos de manipulación de alimentos—especialmente los protocolos de saneamiento y verificación de proveedores—para minimizar el riesgo para los clientes.
Estas medidas son una práctica estándar de la industria tras retiros a gran escala, protegiendo tanto la salud pública como la reputación de los restaurantes.
Impactos Extendidos en Industrias Relacionadas

Los procesadores de carne, proveedores de queso y fabricantes de envases asociados con los productos retirados experimentaron reducciones en pedidos y pérdidas de ingresos.
Las industrias secundarias—incluyendo alimentos para mascotas, alimento para ganado y fertilizantes—se vieron afectadas a medida que disminuían los subproductos de la cadena de suministro de comidas de pasta. Los analistas del mercado esperan una recuperación gradual del sector pendiente de reformas regulatorias.
Consumidores De Todo El Mundo Toman Nota

Los compradores internacionales de alimentos de conveniencia estadounidenses aumentaron los controles de seguridad y exigieron nueva documentación para las importaciones.
Los supermercados europeos y asiáticos retrasaron el lanzamiento de productos o emitieron avisos locales, reflejando una nerviosismo generalizado. Los exportadores respondieron mejorando sus informes y estableciendo comunicación directa con socios internacionales.
Hábitos Alimenticios Más Seguros Entre Los Estadounidenses

El brote llevó a muchos hogares estadounidenses a preferir ingredientes frescos y comidas caseras. Nutricionistas y expertos en seguridad alimentaria reportaron un creciente interés en la educación básica sobre seguridad alimentaria y productos con etiquetas limpias.
Los tutoriales de planificación de comidas y los clubes de cocina registraron una mayor participación, lo que sugiere cambios de estilo de vida a más largo plazo.
Debate Cultural Sobre La Seguridad Alimentaria

Voces de grupos de defensa, líderes de la industria y consumidores reavivaron el diálogo en torno a la seguridad alimentaria industrial.
Algunos pidieron un etiquetado más preciso de los productos, mientras que otros solicitaron transparencia gubernamental en las investigaciones de brotes y auditorías a proveedores.
Los activistas ambientales vincularon la crisis a debates más amplios sobre sistemas alimentarios sostenibles y la responsabilidad corporativa.
Pérdidas Sustanciales

Las granjas y productores locales disfrutaron de un aumento en la demanda de consumidores preocupados por los alimentos procesados. Las grandes marcas y fabricantes nacionales mencionados en el retiro sufrieron pérdidas financieras sustanciales, vieron caer el valor de sus acciones y enfrentaron daños reputacionales. Los expertos legales pronosticaron demandas por pérdida de ganancias y acciones colectivas de consumidores.
Especulación De Mercado Y Movimientos Financieros

Las acciones de las marcas nacionales de alimentos y proveedores afectados cayeron drásticamente tras la noticia del retiro. Por el contrario, los inversores buscaron oportunidades en servicios de entrega de comidas, redes de productos locales y marcas enfocadas en la transparencia. Los analistas predicen una volatilidad sostenida del mercado y nuevas inversiones en tecnología de seguridad de la cadena de suministro.
Consejos Prácticos Para Los Consumidores

Las agencias de salud pública recomiendan que cualquier persona que haya comprado comidas de pasta retiradas las deseche inmediatamente y esté atenta a síntomas como fiebre, dolores musculares y malestar gastrointestinal.
Las mujeres embarazadas, los adultos mayores y los consumidores inmunocomprometidos deben mantenerse vigilantes. Las listas oficiales de retiro se actualizan con frecuencia por el CDC y la FDA.
¿qué Cambios Podrían Venir a Continuación?

Los expertos en seguridad alimentaria anticipan mejoras regulatorias significativas, incluyendo tecnología de trazabilidad mejorada, auditorías a proveedores y sistemas de retiro rápidos en toda la industria.
El Congreso y las agencias están presionando para leyes proactivas en lugar de reactivas, sugiriendo que el brote podría reconfigurar permanentemente la política estadounidense sobre alimentos procesados.
Impacto Duradero Del Brote

Con amplias implicaciones para el comercio minorista, las cadenas de suministro, los consumidores y las políticas públicas, el brote de listeria destaca los riesgos complejos asociados con la producción moderna de alimentos.
Sus repercusiones incluyen un mayor escrutinio de los alimentos de conveniencia, nuevas conversaciones en el gobierno y cambios duraderos en la forma en que los estadounidenses compran, preparan y confían en sus comidas.